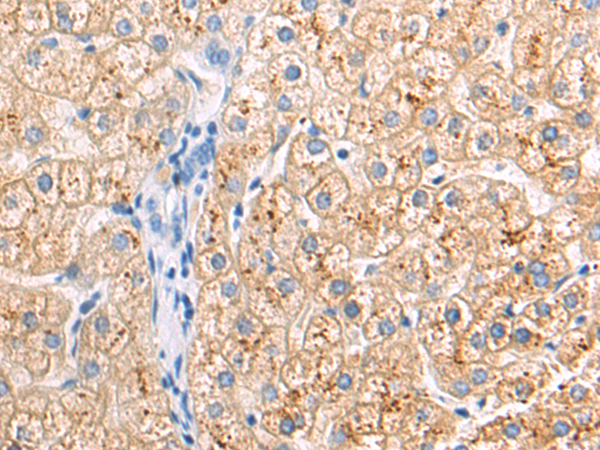

-
分类: 科研抗体货号: P10998别名: CDF, DIA, HILDA, MLPLI应用: IHC反应种属: Human, Mouse, Rat
-
分类: 科研抗体货号: P11014别名: sMAP; MAP19; MASP-2; MASP1P1应用: IHC反应种属: Human, Mouse, Rat
-
分类: 科研抗体货号: P10992别名: SCG10, SCGN10; SCLIP; RB3应用: WB,IHC反应种属: Human, Mouse
-
分类: 科研抗体货号: P11013别名: ASK1, MEKK5, MAPKKK5应用: IHC反应种属: Human, Mouse
-
分类: 科研抗体货号: P10991别名: Lag; SMN; OP18; PP17; PP19; PR22; LAP18; C1orf215应用: WB,IHC反应种属: Human, Mouse, Rat
-
分类: 科研抗体货号: P11012别名: CMP, CRTM应用: IHC反应种属: Human
-
分类: 科研抗体货号: P10990别名: CD223应用: WB反应种属: Human
-
分类: 科研抗体货号: P11011别名: MACAM1应用: WB,IHC反应种属: Human, Mouse
-
分类: 科研抗体货号: P10989别名: E170; LOCS; BM600; LAMNA应用: IHC反应种属: Human, Mouse
-
分类: 科研抗体货号: P11010别名: CR3A; MO1A; CD11B; MAC-1; MAC1A; SLEB6应用: IHC反应种属: Human

鄂公网安备42018502007531号
鄂公网安备42018502007531号

